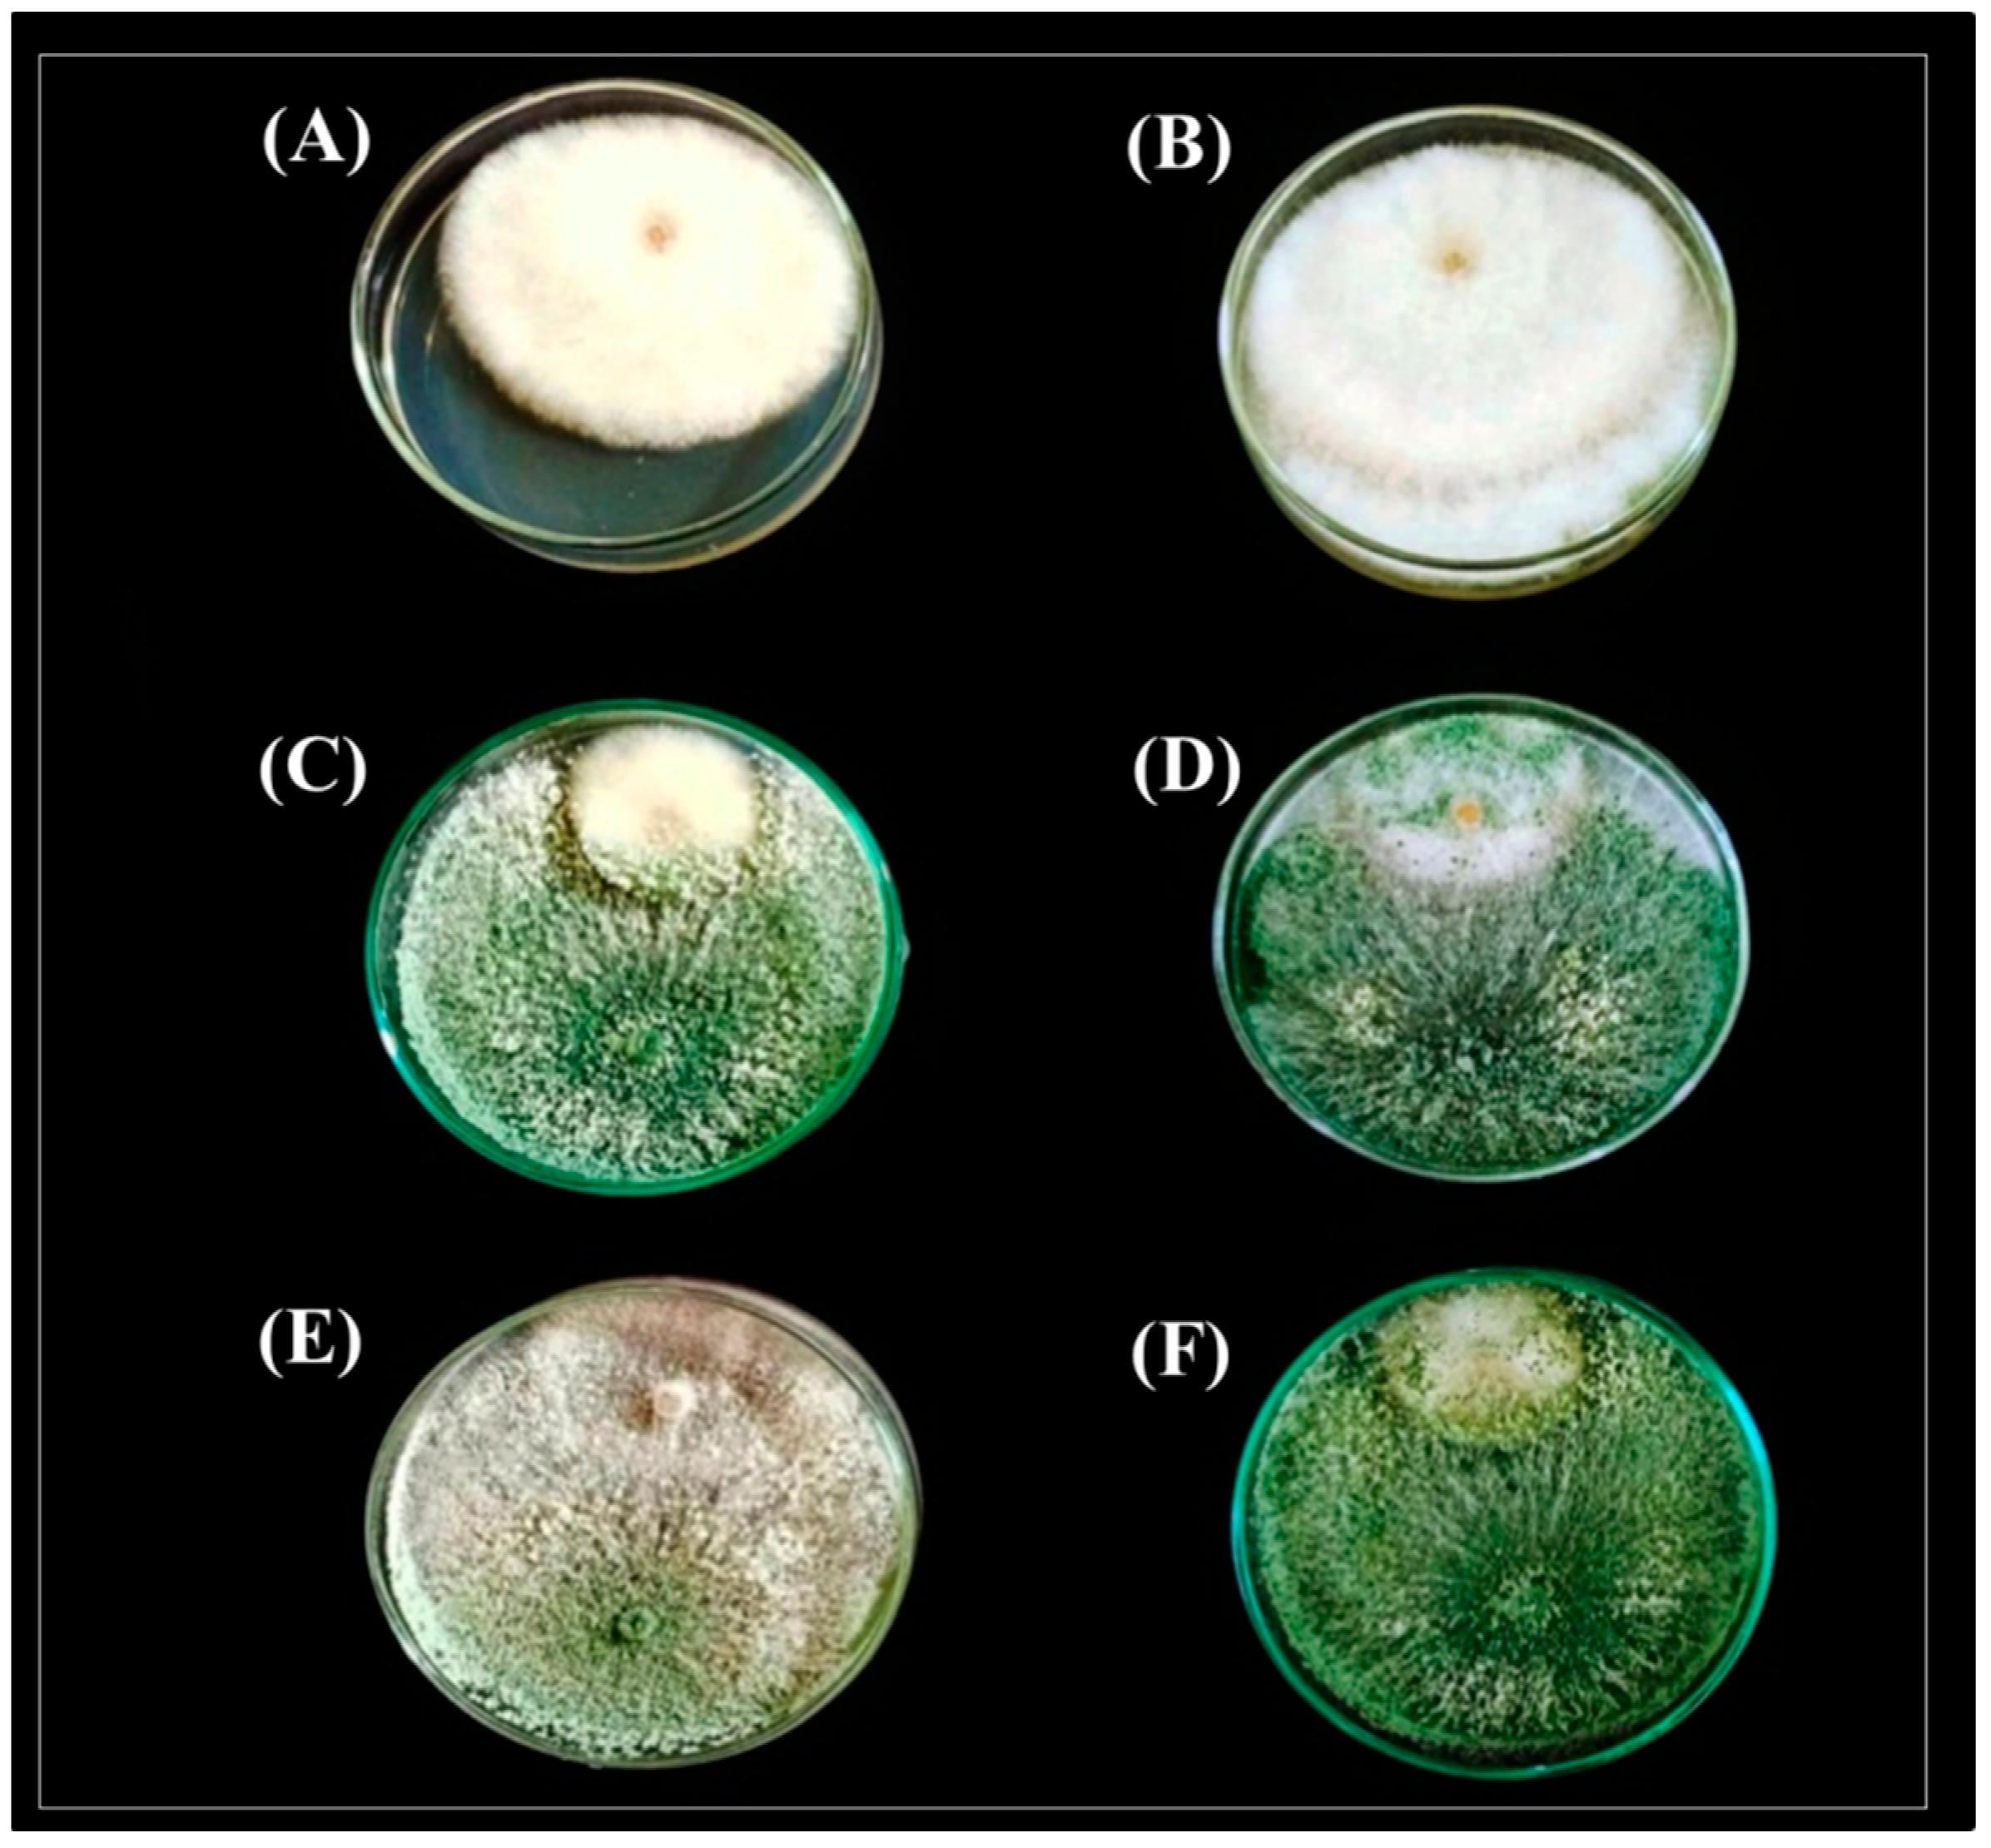

Effective Applications of Trichoderma spp. as Biofertilizers and Biocontrol Agents Mitigate Tomato Fusarium Wilt Disease
Abstract
1. Introduction
2. Materials and Methods
2.1. Isolation of Pathogen and Antagonists
2.2. Molecular Identification of Pathogen and Antagonists
2.2.1. DNA Isolation and ITS Amplification of the Pathogen
2.2.2. PCR-Amplification of (Tef1-α) and (Rpb2) Genes of Trichoderma spp.
2.3. Antagonistic Potential of Trichoderma Isolates against F. solani In Vitro
2.3.1. Dual Culture Assay
2.3.2. Interaction Zones in Dual Cultures by Scanning Electron Microscope
2.4. Effect of Trichoderma Isolates to Manage Tomato Fusarium wilt Disease under Greenhouse Conditions
2.4.1. Inoculum of the Pathogen and Antagonists
2.4.2. Plant Materials, Experimental Conditions, and Design
2.5. Measurements
2.5.1. Plant Disease Incidence (%)
2.5.2. Growth Parameters
2.5.3. Leaves Chemical Composition
2.5.4. Total Phenolic Contents
2.5.5. Analysis of Photosynthetic Pigments
2.6. Statistical Analysis
3. Results
3.1. Identification of Pathogenic fungi F. solani and Biocontrol Agents Trichoderma Isolates
3.2. Antagonistic potential of Trichoderma Isolates against F. solani In Vitro
3.2.1. Dual Culture Assay
3.2.2. Interaction Zone between F. Solani and Trichoderma by Scanning Electron Microscope
3.3. Effect of Trichoderma Isolates to Manage Tomato Fusarium wilt Disease under Greenhouse Conditions
3.3.1. Plant Disease Incidence (%)
3.3.2. Cherry Tomato Growth Parameters
3.3.3. Leaves Chemical Composition
3.3.4. Total Phenolic Contents and Photosynthetic Pigments
4. Discussion
5. Conclusions
Author Contributions
Funding
Institutional Review Board Statement
Data Availability Statement
Conflicts of Interest
References
- Ajilogba, C.F.; Babalola, O.O. Integrated Management Strategies for Tomato Fusarium Wilt. Biocontrol Sci. 2013, 18, 117–127. [Google Scholar] [CrossRef]
- Abou-Zeid, N.M.; Mahmoud, N.A.; Eid, H.T.; Abbas, M.S.; Soliman, A.S. Induction of systematic resistance against tomato root rot disease under greenhouse conditions. Zagazig J. Agric. Res. 2018, 45, 931–944. [Google Scholar] [CrossRef]
- Rahman, M.Z.; Ahmad, K.; Bashir Kutawa, A.; Siddiqui, Y.; Saad, N.; Geok Hun, T.; Hata, E.M.; Hossain, M.I. Biology, Diversity, Detection and Management of Fusarium oxysporum f. sp. niveum Causing Vascular Wilt Disease of Water-melon (Citrullus lanatus): A Review. Agronomy 2021, 11, 1310. [Google Scholar] [CrossRef]
- Egel, D.S.; Martyn, R.D. Fusarium wilt of watermelon and other cucurbits. Plant Health Instr. 2007, 10, 1094. [Google Scholar] [CrossRef]
- Attia, M.S.; Abdelaziz, A.M.; Al-Askar, A.A.; Arishi, A.A.; Abdelhakim, A.M.; Hashem, A.H. Plant Growth-Promoting Fungi as Biocontrol Tool against Fusarium Wilt Disease of Tomato Plant. J. Fungi 2022, 8, 775. [Google Scholar] [CrossRef]
- Niu, B.; Wang, W.; Yuan, Z.; Sederoff, R.R.; Sederoff, H.; Chiang, V.L.; Borriss, R. Microbial Interactions within Multiple-Strain Biological Control Agents Impact Soil-Borne Plant Disease. Front. Microbiol. 2020, 11, 585404. [Google Scholar] [CrossRef]
- Attia, M.S.; El-Wakil, D.A.; Hashem, A.H.; Abdelaziz, A.M. Antagonistic Effect of Plant Growth-Promoting Fungi Against Fusarium Wilt Disease in Tomato: In vitro and In vivo Study. Appl. Biochem. Biotechnol. 2022, 194, 5100–5118. [Google Scholar] [CrossRef]
- Kriaa, M.; Hammami, I.; Sahnoun, M.; Azebou, M.C.; Triki, M.A.; Kammoun, R. Biocontrol of tomato plant diseases caused by Fusarium solani using a new isolated Aspergillus tubingensis CTM 507 glucose oxidase. Comptes Rendus. Biol. 2015, 338, 666–677. [Google Scholar] [CrossRef]
- Awad-Allah, E.F.A.; Shams, A.H.M.; Helaly, A.A. Suppression of Bacterial Leaf Spot by Green Synthesized Silica Nanoparticles and Antagonistic Yeast Improves Growth, Productivity and Quality of Sweet Pepper. Plants 2021, 10, 1689. [Google Scholar] [CrossRef]
- Chen, J.; Zhou, L.; Din, I.U.; Arafat, Y.; Li, Q.; Wang, J.; Wu, T.; Wu, L.; Wu, H.; Qin, X.; et al. Antagonistic activity of Trichoderma spp. against Fusarium oxysporum in rhizosphere of Radix pseudostellariae triggers the expression of host defense genes and improves its growth under long-term monoculture system. Front. Microbiol. 2021, 12, 579920. [Google Scholar] [CrossRef]
- Tseng, Y.-H.; Rouina, H.; Groten, K.; Rajani, P.; Furch, A.C.U.; Reichelt, M.; Baldwin, I.T.; Nataraja, K.N.; Uma Shaanker, R.; Oelmüller, R. An endophytic Trichoderma strain promotes growth of its hosts and defends against pathogen attack. Front. Plant Sci. 2020, 11, 573670. [Google Scholar] [CrossRef] [PubMed]
- Samolski, I.; Rincón, A.M.; Pinzón, L.M.; Viterbo, A.; Monte, E. The qid74 gene from Trichoderma harzianum has a role in root architecture and plant biofertilization. Microbiology 2012, 158, 129–138. [Google Scholar] [CrossRef] [PubMed]
- Ruano-Rosa, D.; Prieto, P.; Rincón, A.M.; Gómez-Rodríguez, M.V.; Valderrama, R.; Barroso, J.B.; Mercado-Blanco, J. Fate of Trichoderma harzianum in the olive rhizosphere: Time course of the root colonization process and interaction with the fungal pathogen Verticillium dahliae. BioControl 2016, 61, 269–282. [Google Scholar] [CrossRef]
- Prakash, O.; Sharma, R.; Rahi, P.; Karthikeyen, N. Role of microorganisms in plant nutrition and health. In Nutrient Use Efficiency: From Basics to Advances; Rakshit, A., Singh, H.B., Sen, A., Eds.; Springer India: New Delhi, India, 2015; pp. 125–161. [Google Scholar] [CrossRef]
- Rajamanikyam, M.; Vadlapudi, V.; Amanchy, R.; Upadhyayula, S.M. Endophytic fungi as novel resources of natural therapeutics. Braz. Arch. Biol. Technol. 2017, 60, e17160542. [Google Scholar] [CrossRef]
- Zin, N.A.; Badaluddin, N.A. Biological functions of Trichoderma spp. for agriculture applications. Ann. Agric. Sci. 2020, 65, 168–178. [Google Scholar] [CrossRef]
- Leslie, J.F.; Summerell, B.A. The Fusarium Laboratory Manual; Blackwell Publishing Professional: Hoboken, NJ, USA, 2006; p. 212. [Google Scholar] [CrossRef]
- Sallam, N.M.A.; Eraky, A.M.I.; Sallam, A. Effect of Trichoderma spp. on Fusarium wilt disease of tomato. Mol. Biol. Rep. 2019, 46, 4463–4470. [Google Scholar] [CrossRef] [PubMed]
- Liu, Y.J.; Whelen, S.; Hall, B.D. Phylogenetic relationships among ascomycetes: Evidence from an RNA polymerse II subunit. Mol. Biol. Evol. 1999, 16, 1799–1808. [Google Scholar] [CrossRef] [PubMed]
- Heflish, A.A.; Abdelkhalek, A.; Al-Askar, A.A.; Behiry, S.I. Protective and Curative Effects of Trichoderma asperelloides Ta41 on Tomato Root Rot Caused by Rhizoctonia solani Rs33. Agronomy 2021, 11, 1162. [Google Scholar] [CrossRef]
- Sambrook, J.; Fritsch, E.F.; Maniatis, T. Molecular Cloning: A Laboratory Manual, 2nd ed.; Cold Spring Harbor Laboratory, ColdSpring: Berlin/Heidelberg, Germany, 1989. [Google Scholar]
- White, T.J.; Bruns, T.; Lee, S.; Taylor, J. PCR Protocols: A Guide to Methods and Applications; Innis, M.A., Gelfand, D.H., Shinsky, J.J., White, T.J., Eds.; Academic Press: San Diego, CA, USA, 1990; pp. 315–322. [Google Scholar] [CrossRef]
- Kumar, S.; Stecher, G.; Li, M.; Knyaz, C.; Tamura, K. MEGA X: Molecular evolutionary genetics analysis across computing platforms. Mol. Biol. Evol. 2018, 35, 1547–1549. [Google Scholar] [CrossRef]
- Jaklitsch, W.M.; Samuels, G.J.; Dodd, S.L.; Lu, B.; Druzhinina, I.S. Hypocrea rufa/Trichoderma viride: A reassessment, and description of five closely related species with and without warted conidia. Stud. Mycol. 2006, 55, 135–177. [Google Scholar] [CrossRef]
- Oskiera, M.; Szczech, M.; Bartoszewski, G. Molecular identification of Trichoderma strains collected to develop plant growth-promoting and biocontrol agents. J. Hortic. Res. 2015, 23, 75–86. [Google Scholar] [CrossRef]
- Nofal, A.M.; Abdelghany, T.M.; Abd-EL-Hamed, W.F.M. Significance of local Trichoderma isolates in controlling Pythium ultimum and Rhizoctonia solani on bean in Egypt. Egypt. J. Phytopathol. 2021, 49, 131–140. [Google Scholar] [CrossRef]
- Aamir, M.; Kashyap, S.P.; Zehra, A.; Dubey, M.K.; Singh, V.K.; Ansari, W.A.; Upadhyay, R.S.; Singh, S. Trichoderma erinaceum Bio-Priming Modulates the WRKYs Defense Programming in Tomato Against the Fusarium oxysporum f. sp. lycopersici (Fol) Challenged Condition. Front. Plant Sci. 2019, 10, 911. [Google Scholar] [CrossRef] [PubMed]
- Nofal, A.M.; Abd El-Rahman, M.; Abdelghany, T.M.; Abd El-Mongy, M. Mycoparasitic nature of Egyptian Trichoderma isolates and their impact on suppression Fusarium wilt of tomato. Egypt. J. Biol. Pest Control 2021, 31, 103. [Google Scholar] [CrossRef]
- El-Komy, M.H.; Al-Qahtani, R.M.; Ibrahim, Y.E.; Almasrahi, A.A.; Al-Saleh, M.A. Soil application of Trichoderma asperellum strains significantly improves Fusarium root and stem rot disease management and promotes growth in cucumbers in semi-arid regions. Eur. J. Plant Pathol. 2022, 162, 637–653. [Google Scholar] [CrossRef]
- Hewitt, E.J. Sand and Water Culture Methods Used in the Study of Plant Nutrition; Technical Communication No.22; Commonwealth Bureau: London, UK, 1966. [Google Scholar]
- Song, W.; Zhou, L.; Yang, C.; Cao, X.; Zhang, L.; Liu, X. Tomato Fusarium Wilt and its chemical control strategies in a hydroponic system. Crop Prot. 2004, 23, 243–247. [Google Scholar] [CrossRef]
- Chapman, H.D.; Pratt, P.F. Methods of Analysis for soils, Plants and Waters; Division of Agricultural Science, University of California: Los Angeles, CA, USA, 1961. [Google Scholar]
- Jones, J.B., Jr. Laboratory Guide for Conducting Soil Tests and Plant Analysis; CRC Press: Boca Raton, FL, USA, 2001. [Google Scholar]
- Page, A.L.; Miller, R.H.; Keeney, D.R. Methods of Soil Analysis. Part 2: Chemical and Microbiological Properties, 2nd ed.; Agron. No. 9 (Part 2) in the Agronomy Series; ASA, SSSA, Inc.:: Madison, WI, USA, 1982. [Google Scholar]
- Malik, C.P.; Singh, M.B. Plant Enzymology and Histo-Enzymology, 1st ed.; Kalyani Publishers: New Delhi, India, 1980; p. 286. [Google Scholar]
- Horowitz, W. Official Methods of Analysis of the Association of Official Analytical Chemists, 12th ed.; Association of Official Analytical Chemists: Washington, DC, USA, 1975. [Google Scholar]
- CoStat Software, version 6.303; Microcomputer Program Analysis; CoHort Software: Monterey, CA, USA, 2004.
- Gomez, K.A.; Gomez, A.A. Statistical Procedures for Agricultural Research, 2nd ed.; A Wiley−Interscience Publication; John Wiley and Sons: New York, NY, USA, 1984. [Google Scholar]
- Abdel-lateif, K.S. Trichoderma as biological control weapon against soil borne plant pathogens. Afr. J. Biotechnol. 2017, 16, 2299–2306. [Google Scholar] [CrossRef]
- Benítez, T.; Rincón, A.M.; Limón, M.C.; Codon, A.C. Biocontrol mechanisms of Trichoderma strains. Int. Microbiol. 2004, 7, 249–260. [Google Scholar] [CrossRef] [PubMed]
- Mukhopadhyay, R.; Kumar, D. Trichoderma: A beneficial antifungal agent and insights into its mechanism of biocontrol potential. Egypt. J. Biol. Pest Control 2020, 30, 1–8. [Google Scholar] [CrossRef]
- Parmar, H.J.; Bodar, N.P.; Lakhani, H.N.; Patel, S.V.; Umrania, V.V.; Hassan, M.M. Production of lytic enzymes by Trichoderma strains during in vitro antagonism with Sclerotium rolfsii, the causal agent of stem rot of groundnut. Afr. J. Microbiol. Res. 2015, 9, 365–372. [Google Scholar] [CrossRef]
- Srivastava, M.; Kumar, V.; Shahid, M.; Pandey, S.; Singh, A. Trichoderma- a potential and effective bio fungicide and alternative source against notable phytopathogens: A review. Afr. J. Agric. Res. 2016, 11, 310–316. [Google Scholar] [CrossRef]
- Lorito, M.; Woo, S. Trichoderma: A Multi-Purpose Tool for Integrated Pest Management. In Principles of Plant-Microbe Interactions; Lugtenberg, B., Ed.; Springer: Cham, Switzerland, 2015. [Google Scholar] [CrossRef]
- Meher, J.; Rajput, R.S.; Bajpai, R.; Teli, B.; Sarma, B.K. Trichoderma: A globally dominant commercial biofungicide. In Trichoderma: Agricultural Applications and Beyond; Soil Biology; Manoharachary, C., Singh, H.B., Varma, A., Eds.; Springer Nature: Cham, Switzerland, 2020; Volume 61. [Google Scholar] [CrossRef]
- Abdullah, N.S.; Doni, F.; Mispan, M.S.; Saiman, M.Z.; Yusuf, Y.M.; Oke, M.A.; Suhaimi, N.S.M. Harnessing Trichoderma in agriculture for productivity and sustainability. Agronomy 2021, 11, 2559. [Google Scholar] [CrossRef]
- Puyam, A. Advent of Trichoderma as a bio-control agent—A review. J. Appl. Nat. Sci. 2016, 8, 1100–1109. [Google Scholar] [CrossRef]
- Zhou, Y.; Yang, L.; Wang, J.; Guo, L.; Huang, J. Synergistic Effect between Trichoderma virens and Bacillus velezensis on the Control of Tomato Bacterial Wilt Disease. Horticulturae 2021, 7, 439. [Google Scholar] [CrossRef]
- Xu, X.M.; Jeger, M.J. Combined use of two biocontrol agents with different biocontrol mechanisms most likely results in less than expected efficacy in controlling foliar pathogens under fluctuating conditions: A modeling study. Phytopathology 2013, 103, 108–116. [Google Scholar] [CrossRef] [PubMed][Green Version]
- Singh, S.P.; Pandey, S.; Mishra, N.; Giri, V.P.; Mahfooz, S.; Bhattacharya, A.; Kumari, M.; Chauhan, P.; Verma, P.; Nautiyal, C.S.; et al. Supplementation of Trichoderma improves the alteration of nutrient allocation and transporter genes expression in rice under nutrient deficiencies, Plant Physiol. Biochem. 2019, 143, 351–363. [Google Scholar] [CrossRef]
- Kour, D.; Rana, K.L.; Yadav, A.N.; Yadav, N.; Kumar, M.; Kumar, V.; Vyas, P.; Dhaliwal, H.S.; Saxena, A.K. Microbial biofertilizers: Bioresources and eco-friendly technologies for agricultural and environmental sustainability. Biocatal. Agric. Biotechnol. 2020, 23, 101487. [Google Scholar] [CrossRef]
- Datnoff, L.E.; Elmer, W.H.; Huber, D.M. Mineral Nutrition and Plant Disease; APS Press, The American Phytopathological Society: St. Paul, MN, USA, 2007. [Google Scholar]
- Fageria, N.K. The Use of Nutrients in Crop Plants; CRC Press: Boca Raton, FL, USA; Taylor and Francis Group: London, UK, 2009. [Google Scholar]
- Mostafa, D.M.; Awd Allah, S.F.A.; Awad-Allah, E.F.A. Potential of Pleurotus sajor-caju compost for controlling Meloidogyne incognita and improve nutritional status of tomato plants. J. Plant Sci. Phytopathol. 2019, 3, 118–127. [Google Scholar] [CrossRef]
- Chowdhury, M.S.R.; Rahman, M.A.; Nahar, K.; Dastogeer, K.M.G.; Hamim, I.; Mohiuddin, K.M. Mineral nutrient content of infected plants and allied soils provide insight into wheat blast epidemics. Heliyon 2022, 8, e08966. [Google Scholar] [CrossRef]
- Zhang, F.; Huo, Y.; Cobb, A.B.; Luo, G.; Zhou, J.; Yang, G.; Wilson, G.W.; Zhang, Y. Trichoderma biofertilizer links to altered soil chemistry, altered microbial communities, and improved grassland biomass. Front. Microbiol. 2018, 9, 848. [Google Scholar] [CrossRef] [PubMed]
- Mehetre, S.T.; Mukherjee, P.K. Trichoderma improves nutrient use efficiency in crop plants. In Nutrient Use Efficiency: From Basics to Advances; Rakshit, A., Singh, H.B., Sen, A., Eds.; Springer: New Delhi, India, 2015; pp. 173–180. [Google Scholar] [CrossRef]
- Bláha, L. Importance of root-shoot ratio for crops production. J. Agron. Agri. Sci. 2019, 2, 12. [Google Scholar] [CrossRef]
- Awad-Allah, E.F.; Elsokkary, I.H. Influence of potassium nutrition and exogenous organic acids on iron uptake by monocot and dicot plants. Open J. Soil Sci. 2020, 10, 486–500. [Google Scholar] [CrossRef]
- Lattanzio, V.; Lattanzio, V.M.; Cardinali, A. Role of phenolics in the resistance mechanisms of plants against fungal pathogensand insects. Phytochem. Adv. Res. 2006, 661, 23–67. [Google Scholar]
- Mikulic-Petkovsek, M.; Schmitzer, V.; Stampar, F.; Veberic, R.; Koron, D. Changes in phenolic content induced by infection with Didymella applanata and Leptosphaeria coniothyrium, the causal agents of raspberry spur and cane blight. Plant Pathol. 2014, 63, 185–192. [Google Scholar] [CrossRef]
- Hijaz, F.; Al-Rimawi, F.; Manthey, J.A.; Killiny, N. Phenolics, flavonoids and antioxidant capacities in Citrus species with different degree of tolerance to Huanglongbing. Plant Signal. Behav. 2020, 15, 1752447. [Google Scholar] [CrossRef] [PubMed]
- Ortega-García, J.G.; Montes-Belmont, R.; Rodríguez-Monroy, M.; Ramírez-Trujillo, J.A.; Suárez-Rodríguez, R.; Sepúlveda-Jiménez, G. Effect of Trichoderma asperellum applications and mineral fertilization on growth promotion and the content of phenolic compounds and flavonoids in onions. Sci. Hortic. 2015, 195, 8–16. [Google Scholar] [CrossRef]
- Yedidia, I.; Shoresh, M.; Kerem, Z.; Benhamou, N.; Kapulnik, Y.; Chet, I. Concomitant induction of systemic resistance to Pseudomonas syringae pv. lachrymans in cucumber by Trichoderma asperellum (T-203) and accumulation of phytoalexins. Appl. Environ. Microbiol. 2003, 69, 7343–7353. [Google Scholar] [CrossRef] [PubMed]
- Singh, B.N.; Singh, A.; Singh, S.P.; Singh, H.B. Trichoderma harzianum- mediated reprogramming of oxidative stress response in root apoplast of sunflower enhances defiance against Rhizoctonia solani. Eur. J. Plant Pathol. 2011, 131, 121–134. [Google Scholar] [CrossRef]
- Shahriar, S.A.; Islam, M.N.; Chun, C.N.W.; Kaur, P.; Rahim, M.A.; Islam, M.M.; Uddain, J.; Siddiquee, S. Microbial Metabolomics Interaction and Ecological Challenges of Trichoderma Species as Biocontrol Inoculant in Crop Rhizosphere. Agronomy 2022, 12, 900. [Google Scholar] [CrossRef]

) F. solani hyphae, (
) Trichoderma spp. hyphae, (
) the Trichoderma hyphae coiled or attach to the F. solani hyphae, (
) degradation and deformation of F. solani hyphae are caused by Trichoderma spp. activity.
) F. solani hyphae, (
) Trichoderma spp. hyphae, (
) the Trichoderma hyphae coiled or attach to the F. solani hyphae, (
) degradation and deformation of F. solani hyphae are caused by Trichoderma spp. activity.


| Primer Name | Gene | Primer Direction | Sequence (5′-3′) |
|---|---|---|---|
| Internal Transcribed Spacer | ¶ ITS | ITS1/ITS4 | TCCGTAGGTGAACCTGCGG/ TCCTCCGCTTATTGATATGC |
| RNA polymerase II subunit 2 | Rpb2 | fRPB2-5f/fRPB2-7cr | GAYGAYMGWGATCAYTTYGG/ CCCATRGCTTGYTTRCCCAT |
| Translation elongation factor 1-α | Tef1-α | EF1-728F/TEF1LLErev | CATCGAGAAGTTCGAGAAGG/ AACTTGCAGGCAATGTGG |
| Treatments | Fresh Weight (g Plant−1) | Dry Weight (g Plant−1) | ||||||
|---|---|---|---|---|---|---|---|---|
| F. solani Infection | Trichoderma Isolates | Shoots | Roots | Whole Plant | Shoots | Roots | Whole Plant | Root-Shoot Ratio |
| Without | T0 | 132 ± 1.67 e | 78 ± 0.71 e | 210 ± 1.52 e | 64 ± 2.07 f | 40 ± 1.78 e | 103 ± 1.95 f | 0.63 ± 0.01 d |
| T1 | 155 ± 1.68 d | 103 ± 1.82 d | 257 ± 3.42 d | 70 ± 0.84 e | 50 ± 0.70 d | 120 ± 1.48 e | 0.71 ± 0.02 c | |
| T2 | 184 ± 1.67 b | 128 ± 1.67 b | 311 ± 1.79 b | 86 ± 2.51 b | 69 ± 1.67 b | 154 ± 1.30 b | 0.80 ± 0.01 b | |
| TMix1+2 | 199 ± 2.51 a | 136 ± 1.52 a | 334 ± 3.35 a | 95 ± 1.82 a | 85 ± 2.50 a | 179 ± 2.39 a | 0.89 ± 0.03 a | |
| With | T0 | 105 ± 1.82 f | 55 ± 1.81 f | 159 ± 3.11 f | 50 ± 0.71 h | 25 ± 1.79 g | 75 ± 2.17 h | 0.50 ± 0.02 f |
| T1 | 130 ± 1.87 e | 80 ± 1.82 e | 210 ± 1.82 e | 59 ± 0.70 g | 36 ± 1.67 f | 95 ± 2.07 g | 0.61 ± 0.01 e | |
| T2 | 156 ± 1.81 d | 103 ± 0.71 d | 260 ± 0.89 d | 73 ± 0.71 d | 51 ± 0.71 d | 124 ± 0.71 d | 0.70 ± 0.01 c | |
| TMix1+2 | 175 ± 1.82 c | 120 ± 1.87 c | 295 ± 2.19 c | 84 ± 2.61 c | 66 ± 2.51 c | 150 ± 3.67 c | 0.79 ± 0.02 b | |
| Treatments | Leaf Chemical Composition of Cherry Tomato Plants | ||||||||
|---|---|---|---|---|---|---|---|---|---|
| F. solani Infection | Trichoderma Isolates | (%) | (µg/g), of D.W. | ||||||
| N | P | K | Ca | Mg | Fe | Zn | Cu | ||
| Without | T0 | 3.58 ± 0.02 f | 0.31 ± 0.01 f | 3.00 ± 0.01 f | 0.97 ± 0.02 f | 0.43 ± 0.01 e | 63 ± 0.71 e | 35 ± 0.71 e | 6.24 ± 0.09 f |
| T1 | 3.99 ± 0.02 d | 0.37 ± 0.01 d | 3.38 ± 0.01 d | 1.38 ± 0.02 d | 0.64 ± 0.02 c | 75 ± 1.79 c | 47 ± 1.82 c | 7.12 ± 0.08 d | |
| T2 | 4.47 ± 0.08 b | 0.46 ± 0.01 ab | 3.78 ± 0.04 a | 1.76 ± 0.04 a | 0.71 ± 0.01 b | 86 ± 2.51 b | 52 ± 1.79 b | 8.33 ± 0.15 b | |
| TMix1+2 | 4.71 ± 0.03 a | 0.47 ± 0.02 a | 3.80 ± 0.03 a | 1.78 ± 0.04 a | 0.75 ± 0.03 a | 98 ± 3.65 a | 58 ± 2.86 a | 9.15 ± 0.26 a | |
| With | T0 | 3.21 ± 0.02 g | 0.22 ± 0.03 g | 2.81 ± 0.02 g | 0.82 ± 0.02 g | 0.37 ± 0.01 f | 47 ± 0.70 g | 22 ± 0.70 g | 5.13 ± 0.09 g |
| T1 | 3.79 ± 0.01 e | 0.33 ± 0.01 e | 3.22 ± 0.01 e | 1.12 ± 0.02 e | 0.46 ± 0.02 e | 56 ± 0.71 f | 30 ± 1.87 f | 6.59 ± 0.06 e | |
| T2 | 4.25 ± 0.02 c | 0.41 ± 0.02 c | 3.51 ± 0.02 c | 1.57 ± 0.01 c | 0.55 ± 0.02 d | 71 ± 3.19 d | 41 ± 1.79 d | 7.55 ± 0.07 c | |
| TMix1+2 | 4.42 ± 0.07 b | 0.45 ± 0.01 b | 3.73 ± 0.04 b | 1.69 ± 0.03 b | 0.69 ± 0.04 b | 84 ± 3.17 b | 50 ± 1.78 b | 8.49 ± 0.23 b | |
| Treatments | Photosynthetic Pigments | Total Phenolic Content (mg/g), of F.W. | ||||
|---|---|---|---|---|---|---|
| F. solani Infection | Trichoderma Isolates | Chlorophyll (mg/g), of F.W. | Carotenoids (mg/g), of F.W. | |||
| a | b | Total Chlorophyll | ||||
| Without | T0 | 1.63 ± 0.09 d | 0.70 ± 0.03 d | 2.33 ± 0.11 d | 0.30 ± 0.01 e | 0.67 ± 0.04 h |
| T1 | 1.85 ± 0.10 c | 0.86 ± 0.02 c | 2.71 ± 0.13 c | 0.47 ± 0.01 c | 1.51 ± 0.10 f | |
| T2 | 2.10 ± 0.10 b | 1.12 ± 0.03 b | 3.22 ± 0.12 b | 0.59 ± 0.03 b | 2.10 ± 0.05 e | |
| TMix1+2 | 2.35 ± 0.09 a | 1.30 ± 0.04 a | 3.64 ± 0.13 a | 0.68 ± 0.03 a | 2.41 ± 0.10 c | |
| With | T0 | 1.25 ± 0.10 f | 0.50 ± 0.04 f | 1.74 ± 0.12 f | 0.23 ± 0.01 f | 1.20 ± 0.06 g |
| T1 | 1.54 ± 0.06 e | 0.67 ± 0.03 e | 2.20 ± 0.06 e | 0.35 ± 0.02 d | 2.27 ± 0.08 d | |
| T2 | 1.90 ± 0.07 c | 0.88 ± 0.03 c | 2.78 ± 0.06 c | 0.46 ± 0.01 c | 2.65 ± 0.10 b | |
| TMix1+2 | 2.15 ± 0.10 b | 1.10 ± 0.02 b | 3.25 ± 0.13 b | 0.57 ± 0.03 b | 3.12 ± 0.19 a | |
Publisher’s Note: MDPI stays neutral with regard to jurisdictional claims in published maps and institutional affiliations. |
© 2022 by the authors. Licensee MDPI, Basel, Switzerland. This article is an open access article distributed under the terms and conditions of the Creative Commons Attribution (CC BY) license (https://creativecommons.org/licenses/by/4.0/).
Share and Cite
Awad-Allah, E.F.A.; Shams, A.H.M.; Helaly, A.A.; Ragheb, E.I.M. Effective Applications of Trichoderma spp. as Biofertilizers and Biocontrol Agents Mitigate Tomato Fusarium Wilt Disease. Agriculture 2022, 12, 1950. https://doi.org/10.3390/agriculture12111950
Awad-Allah EFA, Shams AHM, Helaly AA, Ragheb EIM. Effective Applications of Trichoderma spp. as Biofertilizers and Biocontrol Agents Mitigate Tomato Fusarium Wilt Disease. Agriculture. 2022; 12(11):1950. https://doi.org/10.3390/agriculture12111950
Chicago/Turabian StyleAwad-Allah, Eman F. A., Amany H. M. Shams, Amira A. Helaly, and Entsar I. M. Ragheb. 2022. "Effective Applications of Trichoderma spp. as Biofertilizers and Biocontrol Agents Mitigate Tomato Fusarium Wilt Disease" Agriculture 12, no. 11: 1950. https://doi.org/10.3390/agriculture12111950
APA StyleAwad-Allah, E. F. A., Shams, A. H. M., Helaly, A. A., & Ragheb, E. I. M. (2022). Effective Applications of Trichoderma spp. as Biofertilizers and Biocontrol Agents Mitigate Tomato Fusarium Wilt Disease. Agriculture, 12(11), 1950. https://doi.org/10.3390/agriculture12111950

